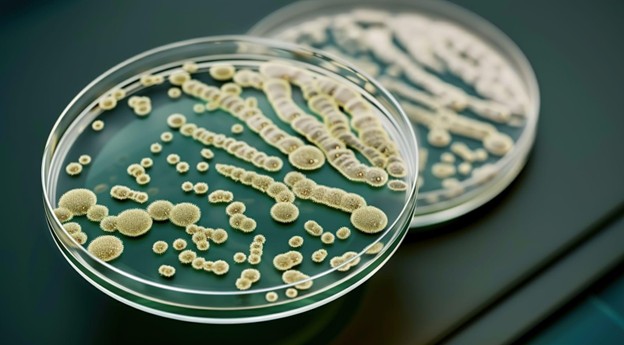
High CFU count results from untreated biofilm in dental unit waterlines

Your cart is currently empty!

Understanding Biofilm Growth, Bacteria, and CFU Counts in Dental Unit Waterlines

SUMMARY: Biofilm in dental unit waterlines (DUWLs) is a significant concern for infection control. Understanding their formation, bacterial contamination, and colony-forming unit (CFU) counts is crucial for maintaining safe water quality in dental practices. The Sterisil® R2A with FASTRead™ mail-in lab test provides a reliable way to monitor and address these issues.
What is Biofilm and How Does It Form in DUWLs?
The Role of Source Water in Biofilm Formation
The water supplied to dental units, often from municipal sources, may contain low levels of bacteria even after treatment. While not immediately harmful, these microorganisms can attach to the inner surfaces of DUWLs and start forming biofilms.
Stagnation and Bacterial Growth
Periods of water stagnation in DUWLs allow bacteria to settle and multiply, creating an ideal environment for biofilm development. This slimy coating consists of bacteria and their extracellular substances, providing a stronghold against disinfectants.

How Bacteria Thrive in Biofilms and Impact CFU Counts
Nutrient Availability and Biofilm Expansion
Bacteria in DUWLs feed on organic materials like saliva, blood, and debris from dental procedures.[CC1] It’s important to note that water entering the dental unit is not sterile, and municipal water, in particular, can contain significant amounts of bacteria. These microorganisms are introduced into the system as water travels through public plumbing and into the dental practice.
Several factors contribute to the growth of biofilm in DUWLs:
- Narrow tubing: The small diameter of the waterlines, combined with a high surface-to-volume ratio, creates a perfect environment for bacteria to cling to and form biofilm.
- Water stagnation: When water sits in the lines for extended periods, such as overnight, it gives bacteria ample time to proliferate and form biofilm.
- Low flow rates: Slow or intermittent water flow can cause bacteria to accumulate and form biofilm over time.
- Suck-back of oral fluids: Negative pressure during procedures, especially when using high-speed handpieces or air/water syringes, can cause fluids from the patient’s mouth—including saliva, blood, and debris—to be sucked back into the waterlines, providing essential nutrients for bacteria.
The Protective Nature of Biofilms
Biofilm creates a shielded environment for bacteria, making it incredibly difficult for standard disinfectants to penetrate and eliminate the microorganisms effectively. Once biofilm forms, it becomes a persistent problem, as the protective layer prevents typical cleaning agents from reaching the bacteria embedded within.
As a result, the colony-forming unit (CFU) counts in untreated or poorly maintained DUWLs can easily exceed recommended safety levels. Given the challenge of removing established biofilms, it’s far more effective to prevent their formation in the first place, which can be achieved by managing bacteria counts and maintaining the lowest possible levels of contamination within the waterlines.
Why CFU Counts Matter in Dental Water Quality
Measuring Bacterial Contamination
Colony-forming units (CFUs) represent the number of viable bacteria in a given water sample. Regulatory guidelines require that procedural water meet the EPA Drinking Water Standard of 500 CFU/mL or below to prevent contamination risks during dental procedures.
Health Risks Associated with High CFU Counts
High CFU levels can lead to bacterial exposure for both patients and dental professionals, increasing the risk of infections, especially for immunocompromised individuals. Aerosols generated during dental procedures can further spread bacteria if water quality is compromised by ineffective treatment that kills both oral and waterline bacteria.[CC1]

How to Prevent and Monitor Biofilm Growth
Regular Waterline Maintenance
Routine flushing, disinfection, and the use of water treatment products like Citrisil™ Shock and the Sterisil® Straw help control biofilm formation and keep CFU counts within safe limits. To help ensure you’re using safe water all the time, Sterisil created a waterline management protocol called the SAFEWater Solution, outlining when and how to test, treat, and maintain your DUWLs.
The Importance of Water Testing
Mail-in water testing with the Sterisil® R2A with FASTRead™ lab test provides dental practices with a clear assessment of their water quality, helping them take corrective actions as needed.

About the Sterisil® R2A with FASTRead™ Test
The Sterisil® R2A with FASTRead™ bacterial test utilizes an EPA-validated R2A plating method to grow and count heterotrophic plate count (HPC) bacterial colonies in water samples collected from dental unit waterlines. All tests are conducted at an EPA-certified third-party lab (#37917).
Each kit includes vials, ice packs, return packaging, a chain of custody form, and detailed instructions, along with a next-day air return shipping label for convenience. Results are available within 5-7 days through the My Solutions Center online portal.
With the new FASTRead™ early notification feature, users receive an alert within 24 hours if their sample exceeds the water safety limit. This enables dental professionals to address microbial growth before it continues to multiply, ensuring timely intervention. FASTRead™ is included with every Sterisil® R2A Waterline test.
Ensuring Safe Dental Water Quality
Biofilm formation and high CFU counts in DUWLs pose a serious risk to dental water safety. Understanding how bacteria thrive, monitoring CFU levels, and implementing proper waterline treatment protocols are essential steps in maintaining compliance and protecting patient health. The Sterisil® R2A with FASTRead™ test offers a fast, reliable solution for assessing and ensuring the quality of your dental water.
FAQs About Biofilm in Dental Unit Waterlines
The CDC recommends keeping CFU levels below 500 CFU/mL to ensure safe dental water quality.
It is recommended to test DUWLs monthly with an in-office test like FASTCheck15™ Waterline Strip Test and quarterly with a R2A test like the Sterisil® R2A with FASTRead™ to ensure compliance and identify potential contamination early.
While biofilm is difficult to eliminate entirely, regular disinfection and water treatment products can significantly reduce its buildup and maintain safe water quality.
The Sterisil® R2A with FASTRead™test is a mail-in lab test that analyzes dental water samples for bacterial contamination and provides rapid results. The FASTRead™ feature offers an early notification if CFU levels exceed safety limits within 24 hours.
Stagnation, nutrient availability, water source contamination, and surface adherence all contribute to biofilm development.
Share this post:




